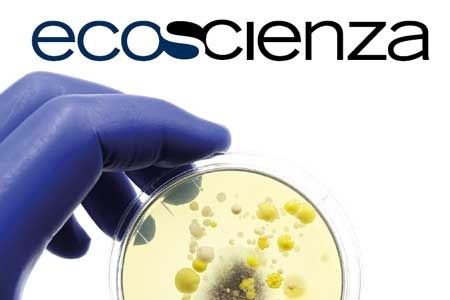
Ecoscienza 3/2025

Ecoscienza - Numero 3 del 2025
I laboratori delle Agenzie ambientali e il loro lavoro in prima linea su fronti critici come la sorveglianza dei virus e dei batteri antibiotico-resistenti, la mappatura delle molecole di antibiotici nelle acque o l’analisi della minaccia delle microplastiche e di nuove sostanze individuate. Un’occasione per fare il punto sul profondo cambiamento che ne ha trasformato e innovato l’organizzazione e le metodologie di indagine. L’altro servizio riguarda il primo protocollo, firmato in Emilia-Romagna, sulle modalità di intervento e le competenze degli enti interessati in caso di emergenze ambientali determinate da incendi, elaborato all’interno Srps tra Arpae, Dipartimenti di sanità pubblica e Istituto zooprofilattico sperimentale. L'attualità si occupa degli ultimi rapporti sul meteo e clima in Europa, Italia ed Emilia-Romagna e di rendicontazione sulla sostenibilità aziendale, in particolare dell’analisi di doppia materialità. A seguire la terza puntata di una riflessione sulla comunicazione della crisi climatica. La rubrica Eco-logos è intitolata "Alexander Langer, un’eredità viva".
https://aggiornati.arpae.it/it/ecoscienza/numeri-ecoscienza/anno-2025/numero-3-anno-2025
https://aggiornati.arpae.it/@@site-logo/nuovo_logo.svg
Ecoscienza - Numero 3 del 2025
I laboratori delle Agenzie ambientali e il loro lavoro in prima linea su fronti critici come la sorveglianza dei virus e dei batteri antibiotico-resistenti, la mappatura delle molecole di antibiotici nelle acque o l’analisi della minaccia delle microplastiche e di nuove sostanze individuate. Un’occasione per fare il punto sul profondo cambiamento che ne ha trasformato e innovato l’organizzazione e le metodologie di indagine. L’altro servizio riguarda il primo protocollo, firmato in Emilia-Romagna, sulle modalità di intervento e le competenze degli enti interessati in caso di emergenze ambientali determinate da incendi, elaborato all’interno Srps tra Arpae, Dipartimenti di sanità pubblica e Istituto zooprofilattico sperimentale. L'attualità si occupa degli ultimi rapporti sul meteo e clima in Europa, Italia ed Emilia-Romagna e di rendicontazione sulla sostenibilità aziendale, in particolare dell’analisi di doppia materialità. A seguire la terza puntata di una riflessione sulla comunicazione della crisi climatica. La rubrica Eco-logos è intitolata "Alexander Langer, un’eredità viva".